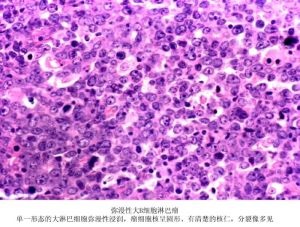
OCI-LY10(OCI-LY-10) 弥漫大B细胞淋巴瘤细胞

网站主页
OCI-LY10(OCI-LY-10) 弥漫大B细胞淋巴瘤细胞
OCI-LY10(OCI-LY-10) 弥漫大B细胞淋巴瘤细胞
OCI-LY10(OCI-LY-10) 弥漫大B细胞淋巴瘤细胞
询价
1000000cells
起订
上海 更新日期:2026-04-05
产品详情:
- 中文名称:
- OCI-LY10(OCI-LY-10) 弥漫大B细胞淋巴瘤细胞
- 产品类别:
- 人细胞系
公司简介
上海盖宁生物科技有限公司主要从事从事免疫学、分子生物学和常规生化试剂的研发及销售,致力于为广大高校、科研院所和企事业单位提供科研试剂和完善的技术服务,满足生物化学、分子生物学 、细胞生物学、免疫学等生物科技实验需求。
上海盖宁生物科技有限公司配有装备完善的实验室、百级净化房‘拥有全球领先的技术资源和经验丰富的研发团队、一整套严格的品质监控体系,确保产品技术的先进和质量的稳定。在广大科研用户的帮助和支持下,经过多年不懈的努力,已经和复旦大学、上海交通大学医学院、四川大学、兰州大学、交通大学、华东师范大学、同济大学等高校医院建立了良好的合作关系。
| 成立日期 | (10年) |
| 注册资本 | 100.000000万人民币 |
| 员工人数 | 50-100人 |
| 年营业额 | ¥ 300万-500万 |
| 经营模式 | 贸易 |
| 主营行业 | 细胞培养,细胞生物学,免疫安全 |
OCI-LY10(OCI-LY-10) 弥漫大B细胞淋巴瘤细胞相关厂家报价 更多
-

- OCI-LY10(人弥漫大B淋巴瘤细胞)
- 澳培赛生物科技(上海)有限公司 VIP
- 2026-04-07
- ¥6500
-

- OCI-LY3人弥漫大B细胞淋巴瘤细胞
- 吉奥蓝图(广东)生命科学技术中心 VIP
- 2026-04-07
- 询价
-

- OCI-Ly10 Cell:人弥漫大B细胞淋巴瘤细胞系
- 上海宾穗生物科技有限公司 VIP
- 2026-04-07
- ¥1287